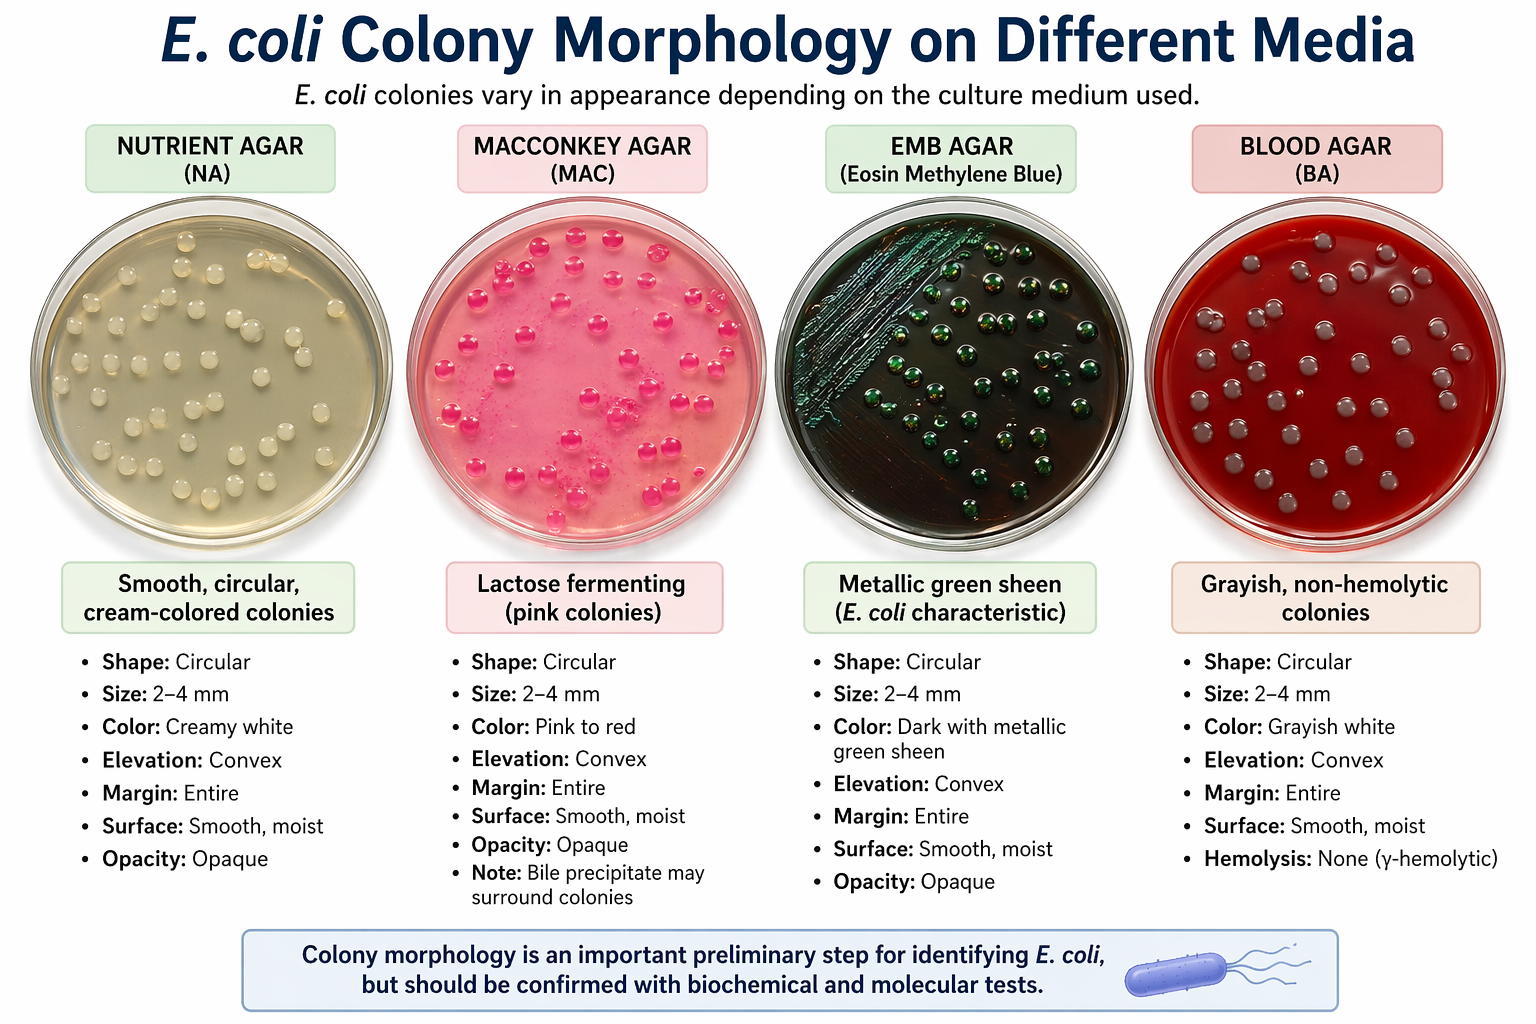

E. coli Colony Morphology: Characteristics, Appearance, and Identification
10th Apr 2026
E. coli Colony Morphology: Characteristics, Appearance, and Identification
Introduction to E. coli Colony Morphology
E. coli colony morphology refers to the visible characteristics of colonies formed by Escherichia coli when grown on solid culture media. These features are essential for microbiologists to identify and differentiate bacteria in laboratory settings.
Understanding colony morphology helps in diagnosis, research, and food safety testing.
Characteristics of E. coli Colony Morphology
On standard media like nutrient agar, Escherichia coli colonies typically show:
- Shape: Circular
- Size: Medium (2–4 mm after 24 hours)
- Margin: Entire (smooth edges)
- Elevation: Slightly raised (convex)
- Surface: Smooth and moist
- Color: Grayish-white to cream
- Opacity: Opaque or slightly translucent
These traits make E. coli relatively easy to recognize in pure culture.
E. coli Colony Morphology on Different Media
1. Nutrient Agar
- Smooth, round colonies
- Creamy white appearance
- Moist texture
2. MacConkey Agar
- Pink to red colonies
- Indicates lactose fermentation
- Often surrounded by bile precipitate
3. EMB Agar (Eosin Methylene Blue)
- Metallic green sheen (distinctive feature)
- Dark purple to black colonies
4. Blood Agar
- Grayish colonies
- Usually non-hemolytic (no RBC destruction)
Factors Affecting Colony Morphology
Several conditions influence how E. coli colonies appear:
- Growth medium composition
- Incubation temperature
- Oxygen availability
- Strain variation
- Incubation time
Changes in these factors can alter colony size, color, and texture.
Importance of E. coli Colony Morphology
Studying colony morphology is crucial for:
- Bacterial identification
- Clinical diagnostics
- Food and water safety testing
- Antibiotic research
- Environmental microbiology
Advantages of Colony Morphology Identification
- Simple and cost-effective
- Rapid preliminary identification
- No advanced equipment needed
Limitations
- Not always specific
- Requires experience
- Similar species may appear alike
Conclusion
E. coli colony morphology provides a quick and reliable way to identify bacteria in laboratory cultures. While it is not definitive alone, it remains a fundamental tool in microbiology.